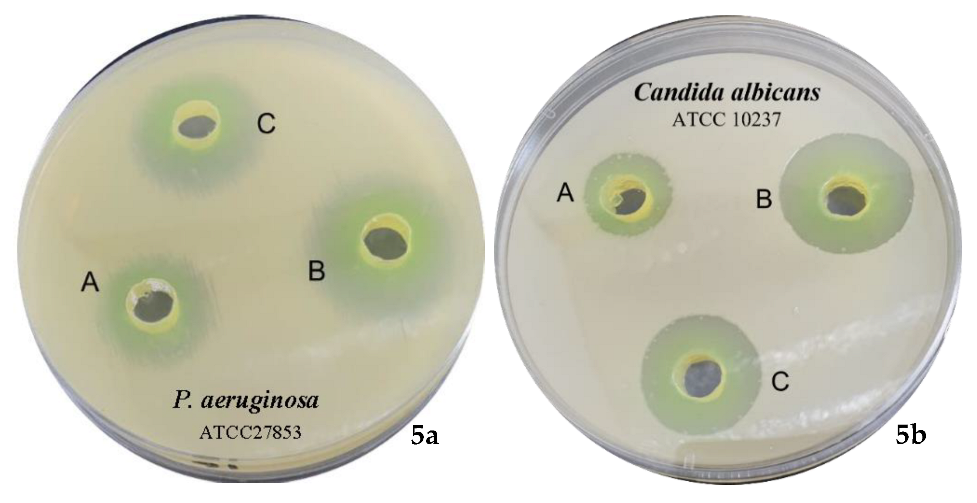
Pharmaceuticals 15 00216 g005

Design, Characterization, and Antimicrobial Evaluation of Copper Nanoparticles Utilizing Tamarixinin a Ellagitannin from Galls of Tamarix aphylla
Abstract
1. Introduction
2. Results and Discussion
2.1. Structural Feature of TA
2.2. Characterization of CuNPs
2.2.1. Visual Observation
2.2.2. UV-Visible Spectroscopy
2.2.3. Particle Size, Zeta Potential, and Polydispersity Index Evaluation
2.2.4. X-ray Diffraction Analysis
2.2.5. Scanning Electron Microscopic Analysis
2.2.6. Antimicrobial Evaluation of TA and Its Mediated CUNPs
3. Materials and Methods
3.1. General Experimental Procedures
3.2. Materials
3.3. Purification of TA
3.4. Spectral Data of TA
3.5. Green Synthesis of CuNPs
3.6. Characterization of TA-Mediated CuNPs
3.6.1. UV-Visible Spectroscopy
3.6.2. Particle Size, Zeta Potential, and Polydispersity Index Evaluation
3.6.3. X-ray Diffraction Analysis
3.6.4. Scanning Electron Microscopic (SEM) Analysis
3.7. Antimicrobial Evaluation
3.7.1. Culture and Microbial Growth
3.7.2. Antimicrobial Assay of TA and TA-Mediated CuNPs
4. Conclusions
Supplementary Materials
Author Contributions
Funding
Institutional Review Board Statement
Informed Consent Statement
Data Availability Statement
Acknowledgments
Conflicts of Interest
References
- Liu, J.; Jiang, J.; Meng, Y.; Aihemaiti, A.; Xu, Y.; Xiang, H.; Gao, Y.; Chen, X. Preparation, environmental application and prospect of biochar-supported metal nanoparticles: A review. J. Hazard. Mater. 2020, 388, 122026. [Google Scholar] [CrossRef] [PubMed]
- Liu, Y.; Crawford, B.M.; Vo-Dinh, T. Gold nanoparticles-mediated photothermal therapy and immunotherapy. Immunotherapy. 2018, 10, 1175–1188. [Google Scholar] [CrossRef] [PubMed]
- Lee, S.H.; Jun, B.H. Silver nanoparticles: Synthesis and application for nanomedicine. Int. J. Mol. Sci. 2019, 20, 865. [Google Scholar] [CrossRef]
- Samrot, A.V.; Sahithya, C.S.; Selvarani, J.; Purayil, S.K.; Ponnaiah, P. A review on synthesis, characterization and potential biological applications of superparamagnetic iron oxide nanoparticles. Curr. Opin. Green Sustain. Chem. 2021, 4, 100042. [Google Scholar] [CrossRef]
- Ogunsona, E.O.; Muthuraj, R.; Ojogbo, E.; Valerio, O.; Mekonnen, T.H. Engineered nanomaterials for antimicrobial applications: A review. Appl. Mater. Today. 2020, 18, 100473. [Google Scholar] [CrossRef]
- Babushkina, I.V.; Mamontova, I.A.; Gladkova, E.V. Metal nanoparticles reduce bacterial contamination of experimental purulent wounds. Bull. Exp. Biol. Med. 2015, 158, 692–694. [Google Scholar] [CrossRef] [PubMed]
- Saranyaadevi, K.; Subha, V.; Ravindran, R.E.; Renganathan, S. Synthesis and characterization of copper nanoparticle using Capparis zeylanica leaf extract. Int. J. Chem. Tech. Res. 2014, 6, 4533–4541. Available online: https://sphinxsai.com/2014/race/2/(4533-4541)%20014.pdf (accessed on 20 December 2021).
- Lee, H.J.; Song, J.Y.; Kim, B.S. Biological synthesis of copper nanoparticles using Magnolia kobus leaf extract and their antibacterial activity. J. Chem. Technol. 2013, 88, 1971–1977. [Google Scholar] [CrossRef]
- Viswadevarayalu, A.; Venkata Ramana, P.; Sreenivasa Kumar, G.; Sumalatha, J.; Adinarayana Reddy, S. Fine ultrasmall copper nanoparticle (UCuNPs) synthesis by using Terminalia bellirica fruit extract and its antimicrobial activity. J. Clust. Sci. 2016, 27, 155–168. [Google Scholar] [CrossRef]
- Dikshit, P.K.; Kumar, J.; Das, A.K.; Sadhu, S.; Sharma, S.; Singh, S.; Gupta, P.K.; Kim, B.S. Green synthesis of metallic nanoparticles: Applications and limitations. Catalysts 2021, 11, 902. [Google Scholar] [CrossRef]
- Raja, P.B.; Rahim, A.A.; Qureshi, A.K.; Awang, K. Green synthesis of silver nanoparticles using tannins. Mater. Sci.-Poland 2014, 32, 408–413. Available online: https://sciendo.com/article/10.2478/s13536-014-0204-2 (accessed on 20 December 2021). [CrossRef]
- Ovais, M.; Khalil, A.T.; Islam, N.U.; Ahmad, I.; Ayaz, M.; Saravanan, M.; Shinwari, Z.K.; Mukherjee, S. Role of plant phytochemicals and microbial enzymes in biosynthesis of metallic nanoparticles. Appl. Microbiol. Biotechnol. 2018, 102, 6799–6814. [Google Scholar] [CrossRef] [PubMed]
- Ahmad, T. Reviewing the tannic acid mediated synthesis of metal nanoparticles. J. Nanotechnol. 2014, 2014, 954206. [Google Scholar] [CrossRef]
- Kim, T.Y.; Cha, S.H.; Cho, S.; Park, Y. Tannic acid-mediated green synthesis of antibacterial silver nanoparticles. Arch. Pharm. Res. 2016, 39, 465–473. [Google Scholar] [CrossRef] [PubMed]
- Orabi, M.A.A.; Yoshimura, M.; Amakura, Y.; Hatano, T. Ellagitannins, gallotannins, and gallo-ellagitannins from the galls of Tamarix aphylla. Fitoterapia 2015, 104, 55–63. [Google Scholar] [CrossRef]
- Akhlaq, M.; Mohammed, A. New phenolic acids from the galls of Tamarix aphylla (L.) Karst. Int. Res. J. Pharm. 2011, 4, 222–225. [Google Scholar]
- Orabi, M.A.A.; Orabi, E.A.; Taniguchi, S.; Sakagami, H.; Yoshimura, M.; Amakura, Y.; Hatano, T. Structures, NMR Spectroscopic Features, and Cytotoxic Properties of Oligomeric Hellinoyl (m-GO-m-GOG)-Type Ellagitannins from the Galls of Tamarix aphylla. J. Nat. Prod. 2019, 82, 2682–2695. [Google Scholar] [CrossRef]
- Yoshida, T.; Ahmed, A.F.; Memon, M.U.; Okuda, T. Tannins of tamaricaceous plants. II. New monomeric and dimeric hydrolyzable tannins from Reaumuria hirtella and Tamarix pakistanica. Chem. Pharm. Bull. 1991, 39, 2849–2854. [Google Scholar] [CrossRef][Green Version]
- Orabi, M.A.A.; Taniguchi, S.; Yoshimura, M.; Yoshida, T.; Kishino, K.; Sakagami, H.; Hatano, T. Hydrolyzable tannins of tamaricaceous plants. III. Hellinoyl-and macrocyclic-type ellagitannins from Tamarix nilotica. J. Nat. Prod. 2010, 73, 870–879. [Google Scholar] [CrossRef]
- Orabi, M.A.A.; Taniguchi, S.; Terabayashi, S.; Hatano, T. Hydrolyzable tannins of tamaricaceous plants. IV: Micropropagation and ellagitannin production in shoot cultures of Tamarix tetrandra. Phytochemistry 2011, 72, 1978–1989. [Google Scholar] [CrossRef] [PubMed]
- Orabi, M.A.A.; Zidan, S.A.; Attia, G.H.; Alyami, H.S.; Matsunami, K.; Hatano, T. Ellagitannins and simple phenolics from the halophytic plant Tamarix nilotica. Nat. Prod. Res. 2021, 36, 177–185. [Google Scholar] [CrossRef] [PubMed]
- Amjad, R.; Mubeen, B.; Ali, S.S.; Imam, S.S.; Alshehri, S.; Ghoneim, M.M.; Alzarea, S.I.; Rasool, R.; Ullah, I.; Nadeem, M.S.; et al. Green synthesis and characterization of copper nanoparticles using Fortunella margarita leaves. Polymers 2021, 13, 4364. [Google Scholar] [CrossRef] [PubMed]
- Mohamed, E.A. Green synthesis of copper & copper oxide nanoparticles using the extract of seedless dates. Heliyon 2020, 6, e03123. [Google Scholar] [CrossRef] [PubMed]
- Ahmed, S.F.; Mofijur, M.; Rafa, N.; Chowdhury, A.T.; Chowdhury, S.; Nahrin, M.; Islam, A.S.; Ong, H.C. Green approaches in synthesising nanomaterials for environmental nanobioremediation: Technological advancements, applications, benefits and challenges. Environ. Res. 2022, 204, 111967. [Google Scholar] [CrossRef] [PubMed]
- Dlamini, N.G.; Basson, A.K.; Pullabhotla, V.S.R. Optimization and application of bioflocculant passivated copper nanoparticles in the wastewater treatment. Int. J. Environ. Res. 2019, 16, 2185. [Google Scholar] [CrossRef]
- Scalbert, A. Antimicrobial properties of tannins. Phytochemistry 1991, 30, 3875–3883. [Google Scholar] [CrossRef]
- Farha, A.K.; Yang, Q.Q.; Kim, G.; Li, H.B.; Zhu, F.; Liu, H.Y.; Gan, R.Y.; Corke, H. Tannins as an alternative to antibiotics. Food Biosci. 2020, 388, 100751. [Google Scholar] [CrossRef]
- Orlowski, P.; Zmigrodzka, M.; Tomaszewska, E.; Ranoszek-Soliwoda, K.; Czupryn, M.; Antos-Bielska, M.; Szemraj, J.; Celichowski, G.; Grobelny, J.; Krzyzowska, M. Tannic acid-modified silver nanoparticles for wound healing: The importance of size. Int. J. Nanomed. 2018, 13, 991. [Google Scholar] [CrossRef]
- Puljula, E.; Walton, G.; Woodward, M.J.; Karonen, M. Antimicrobial activities of ellagitannins against Clostridiales perfringens, Escherichia coli, Lactobacillus plantarum and Staphylococcus aureus. Molecules 2020, 25, 3714. [Google Scholar] [CrossRef]
- Funatogawa, K.; Hayashi, S.; Shimomura, H.; Yoshida, T.; Hatano, T.; Ito, H.; Hirai, Y. Antibacterial activity of hydrolyzable tannins derived from medicinal plants against Helicobacter pylori. Microbiol. Immunol. 2004, 48, 251–261. [Google Scholar] [CrossRef]
- Shiota, S.; Shimizu, M.; Sugiyama, J.I.; Morita, Y.; Mizushima, T.; Tsuchiya, T. Mechanisms of action of corilagin and tellimagrandin I that remarkably potentiate the activity of β-lactams against methicillin-resistant Staphylococcus aureus. Microbiol. Immunol. 2004, 48, 67–73. [Google Scholar] [CrossRef]
- Grass, G.; Rensing, C.; Solioz, M. Metallic copper as an antimicrobial surface. Appl. Environ. Microbiol. 2011, 77, 1541–1547. [Google Scholar] [CrossRef] [PubMed]
- Nisar, P.; Ali, N.; Rahman, L.; Ali, M.; Shinwari, Z.K. Antimicrobial activities of biologically synthesized metal nanoparticles: An insight into the mechanism of action. J. Biol. Inorg. Chem. 2019, 24, 929–941. [Google Scholar] [CrossRef]
- Asghar, M.A.; Asghar, M.A. Green synthesized and characterized copper nanoparticles using various new plants extracts aggravate microbial cell membrane damage after interaction with lipopolysaccharide. Int. J. Biol. Macromol. 2020, 160, 1168–1176. [Google Scholar] [CrossRef] [PubMed]
- Kwon, K.Y.; Cheeseman, S.; Frias-De-Diego, A.; Hong, H.; Yang, J.; Jung, W.; Yin, H.; Murdoch, B.J.; Scholle, F.; Crook, N.; et al. A Liquid metal mediated metallic coating for antimicrobial and antiviral fabrics. Adv. Mater. 2021, 33, 2104298. [Google Scholar] [CrossRef] [PubMed]
- Mali, S.C.; Raj, S.; Trivedi, R. Biosynthesis of copper oxide nanoparticles using Enicostemma axillare (Lam.) leaf extract. Biochem. Biophys. Rep. 2019, 20, 100699. [Google Scholar] [CrossRef]
- Mehtar, S.; Wiid, I.; Todorov, S.D. The antimicrobial activity of copper and copper alloys against nosocomial pathogens and Mycobacterium tuberculosis isolated from healthcare facilities in the Western Cape: An in-vitro study. J. Hosp. Infect. 2008, 68, 45–51. [Google Scholar] [CrossRef] [PubMed]
- Shao, W.; Wang, S.; Wu, J.; Huang, M.; Liu, H.; Min, H. Synthesis and antimicrobial activity of copper nanoparticle loaded regenerated bacterial cellulose membranes. RSC Adv. 2016, 6, 65879–65884. [Google Scholar] [CrossRef]
- Ramyadevi, J.; Jeyasubramanian, K.; Marikani, A.; Rajakumar, G.; Rahuman, A.A. Synthesis and antimicrobial activity of copper nanoparticles. Mater. Lett. 2012, 71, 114–116. [Google Scholar] [CrossRef]
- Doi, A.; Orabi, M.A.A.; Taniguchi, S.; Ogawa, T.; Takeuchi, Y.; Kuroda, T.; Tsuchiya, T.; Ito, H.; Hatano, T. Antibacterial effects of hydrolyzable tannins and related artificial tannins. Pharm. Biol. 2012, 50, 649. [Google Scholar]
- Ouda, S.M. Antifungal activity of silver and copper nanoparticles on two plant pathogens, Alternaria alternata and Botrytis cinerea. Res. J. Microbiol. 2014, 9, 34. [Google Scholar] [CrossRef]
- Santo, C.E.; Taudte, N.; Nies, D.H.; Grass, G. Contribution of copper ion resistance to survival of Escherichia coli on metallic copper surfaces. Appl. Environ. Microbiol. 2008, 74, 977–986. [Google Scholar] [CrossRef] [PubMed]
- Chandrasekaran, R.; Gnanasekar, S.; Seetharaman, P.; Keppanan, R.; Arockiaswamy, W.; Sivaperumal, S. Formulation of Carica papaya latex-functionalized silver nanoparticles for its improved antibacterial and anticancer applications. J. Mol. Liq. 2016, 219, 232–238. [Google Scholar] [CrossRef]
- Fayaz, A.M.; Balaji, K.; Girilal, M.; Yadav, R.; Kalaichelvan, P.T.; Venketesan, R. Biogenic synthesis of silver nanoparticles and their synergistic effect with antibiotics: A study against gram-positive and gram-negative bacteria. Nanomed.: Nanotechnol. Biol. Med. 2010, 6, 103–109. [Google Scholar] [CrossRef] [PubMed]

| Inhibition Zone Diameter (mm) | ||||||
|---|---|---|---|---|---|---|
| Gram-Positive Bacteria | Gram-Negative Bacteria | Fungi | ||||
| B. subtilis NCTC 10400 | S. aureus ATCC 25923 | E. coli ATCC 25922 | P. aeruginosa ATCC 27853 | C. albicans ATCC 10237 | Asp. flavus ATCC 11267 | |
| Tamarixinin A | 9 ± 0.01 | 7 ± 0.03 | 10 ± 0.01 | 11 ± 0.01 | 12 ± 0.03 | 9 ± 0.02 |
| CuNPs | 12 ± 0.03 | 10 ± 0.02 | 18 ± 0.01 | 20 ± 0.04 | 20 ± 0.01 | 16 ± 0.01 |
| Streptomycin | 16 ± 0.00 | 14 ± 0.01 | 16 ± 0.01 | 16 ± 0.02 | ND | ND |
| Ketoconazole | ND | ND | ND | ND | 18 ± 0.02 | 17 ± 0.00 |
| DMSO | No | No | No | No | No | No |
Publisher’s Note: MDPI stays neutral with regard to jurisdictional claims in published maps and institutional affiliations. |
© 2022 by the authors. Licensee MDPI, Basel, Switzerland. This article is an open access article distributed under the terms and conditions of the Creative Commons Attribution (CC BY) license (https://creativecommons.org/licenses/by/4.0/).
Share and Cite
Orabi, M.A.A.; Salem-Bekhit, M.M.; Taha, E.I.; Abdel-Sattar, E.-S.; Alqahtani, O.S.; Al-Joufi, F.A.; Abdel-Wahab, B.A.; Alshabi, A.M.; Alyami, H.S.; Ahmad, J.; et al. Design, Characterization, and Antimicrobial Evaluation of Copper Nanoparticles Utilizing Tamarixinin a Ellagitannin from Galls of Tamarix aphylla. Pharmaceuticals 2022, 15, 216. https://doi.org/10.3390/ph15020216
Orabi MAA, Salem-Bekhit MM, Taha EI, Abdel-Sattar E-S, Alqahtani OS, Al-Joufi FA, Abdel-Wahab BA, Alshabi AM, Alyami HS, Ahmad J, et al. Design, Characterization, and Antimicrobial Evaluation of Copper Nanoparticles Utilizing Tamarixinin a Ellagitannin from Galls of Tamarix aphylla. Pharmaceuticals. 2022; 15(2):216. https://doi.org/10.3390/ph15020216
Chicago/Turabian StyleOrabi, Mohamed A. A., Mounir M. Salem-Bekhit, Ehab I. Taha, El-Shaymaa Abdel-Sattar, Omaish Salman Alqahtani, Fakhria A. Al-Joufi, Basel A. Abdel-Wahab, Ali Mohamed Alshabi, Hamad S. Alyami, Javed Ahmad, and et al. 2022. "Design, Characterization, and Antimicrobial Evaluation of Copper Nanoparticles Utilizing Tamarixinin a Ellagitannin from Galls of Tamarix aphylla" Pharmaceuticals 15, no. 2: 216. https://doi.org/10.3390/ph15020216
APA StyleOrabi, M. A. A., Salem-Bekhit, M. M., Taha, E. I., Abdel-Sattar, E.-S., Alqahtani, O. S., Al-Joufi, F. A., Abdel-Wahab, B. A., Alshabi, A. M., Alyami, H. S., Ahmad, J., & Hatano, T. (2022). Design, Characterization, and Antimicrobial Evaluation of Copper Nanoparticles Utilizing Tamarixinin a Ellagitannin from Galls of Tamarix aphylla. Pharmaceuticals, 15(2), 216. https://doi.org/10.3390/ph15020216

